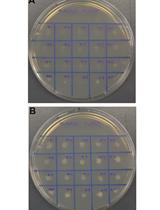
使用CRISPR-Cas9对玉米黑粉菌进行单个和多个基因的编辑

- EN - English
- CN - 中文
Design of Hybrid RNA Polymerase III Promoters for Efficient CRISPR-Cas9 Function
设计合成RNA聚合酶III启动子以高效启动CRISPR-Cas9功能
发布: 2018年03月20日第8卷第6期 DOI: 10.21769/BioProtoc.2779 浏览次数: 9921
评审: David CisnerosMichael TschernerSadri Znaidi
Abstract
The discovery of the CRISPR-Cas9 system from Streptococcus pyogenes has allowed the development of genome engineering tools in a variety of organisms. A frequent limitation in CRISPR-Cas9 function is adequate expression levels of sgRNA. This protocol provides a strategy to construct hybrid RNA polymerase III (Pol III) promoters that facilitate high expression of sgRNA and improved CRISPR-Cas9 function. We provide selection criteria of Pol III promoters, efficient promoter construction methods, and a sample screening technique to test the efficiency of the hybrid promoters. A hybrid promoter system developed for Yarrowia lipolytica will serve as a model.
Keywords: Synthetic biology (合成生物学)Background
CRISPR (Clustered Regularly Interspaced Short Palindromic Repeats) is a collection of DNA sequences found in bacteria that contain snippets of viral DNA from previous exposures (Marraffini and Sontheimer, 2010). The snippets are referred to as spacer DNA, and they are flanked by short, repetitive palindromic sequences. Bacteria use these stored spacer sequences as a template to express RNA to recognize and attack specific viruses if they are exposed again. When combined with CRISPR-associated (Cas) proteins, CRISPR-Cas systems can recognize and cut foreign DNA or RNA, destroying the virus and protecting the host from repeated infections (Barrangou, 2013).
A specific CRISPR system, the type II CRISPR-Cas9 from Streptococcus pyogenes, has been modified into a simpler system for use in genomic editing. With this system, researchers are able to design specific single-guide RNA (sgRNA) sequences that are complementary to a 20 bp sequence of a gene of interest that has an upstream protospacer adjacent motif (PAM; ‘NGG’) (Jinek et al., 2012). When the designed sgRNA complexes with the Cas9 protein, the assembled ribonucleoprotein binds to and introduces a double strand break (DSB) in the target DNA sequence. In genome editing applications, this DSB is then repaired by a cell’s native repair mechanisms. In the absence of an introduced repair template, the nonhomologous end-joining DNA repair pathway is normally used to repair the break in most eukaryotes (Moore and Haber, 1996). Repair via nonhomologous end-joining frequently results in an indel mutation that causes a frameshift mutation and disrupts the gene’s function. The simple programmability of the sgRNA sequences allows for unprecedented precision in genomic edits. In addition, the portability of the CRISPR-Cas9 system has allowed precise genome editing and other applications in organisms where it was previously tedious or impossible (Mali et al., 2013; Wang et al., 2013; Lobs et al., 2017b; Schwartz et al., 2017b and 2017c). The efficiency of the CRISPR-Cas9 system has been shown to correlate with sgRNA expression (Hsu et al., 2013; Ryan et al., 2014; Yuen et al., 2017). Because of this, a range of strategies for sgRNA expression have been developed. RNA polymerase II promoters, which primarily serve to drive expression of mRNA, have been used because they are widely studied and offer a high degree of control over expression (Deaner et al., 2017). More commonly for CRISPR systems, RNA polymerase III (Pol III) promoters have been used to drive sgRNA expression. Pol III promoters natively drive expression of smaller RNAs, most notably tRNAs, and yield higher transcript levels (Schwartz et al., 2016). To increase functional sgRNA expression levels even higher, Pol III promoters concatenated with tRNAs have been used (Xie et al., 2015; Schwartz et al., 2016; Lobs et al., 2017a). Implementation of synthetic hybrid Pol III promoter systems can improve CRISPR-Cas9 mediated genome editing for efficient gene disruption.
Materials and Reagents
- 10 µl pipette tips (Fisher Scientific, FisherbrandTM, catalog number: 02-707-438 )
- 200 µl pipette tips (Fisher Scientific, FisherbrandTM, catalog number: 02-707-417 )
- 1,000 µl pipette tips (Fisher Scientific, FisherbrandTM, catalog number: 02-707-403 )
- 1.5 ml microcentrifuge tubes (Fisher Scientific, FisherbrandTM, catalog number: 05-408-129 )
- 0.2 ml PCR tubes (Fisher Scientific, FisherbrandTM, catalog number: 14-230-215 )
- 100 x 15 mm Petri dishes (Fisher Scientific, FisherbrandTM, catalog number: FB0875712 )
- 14 ml culture tubes (Corning, Falcon®, catalog number: 352057 )
- Competent DH5α Escherichia coli (New England Biolabs, catalog number: C2987I )
- Yarrowia lipolytica strain Po1f (ATCC, catalog number: MYA-2613 )
- pCRISPRyl (Addgene, catalog number: 70007 ) or Episomal Cas9 plasmid (see Notes)
- Q5 HF polymerase (New England Biolabs, catalog number: M0491L )
- YeaStarTM Genomic DNA Kit (Zymo Research, catalog number: D2002 )
- DNA Clean & ConcentratorTM (Zymo Research, catalog number: D4004 )
- Gibson Assembly Master mix (New England Biolabs, catalog number: E2611L )
- ZyppyTM Plasmid Miniprep Kit (Zymo Research, catalog number: D4037 )
- CutSmart Buffer (New England Biolabs, catalog number: B7204S )
- AvrII restriction enzyme (New England Biolabs, catalog number: R0174S )
- Taq DNA polymerase (New England Biolabs, catalog number: M0273L )
- Yeast extract (BD, DifcoTM, catalog number: 212750 )
- Peptone (BD, DifcoTM, catalog number: 211677 )
- Glucose (Fisher Scientific, FisherbrandTM, catalog number: D16-10 )
- Agar (Sigma-Aldrich, catalog number: A7002-1KG )
- Yeast nitrogen base without amino acids (BD, DifcoTM, catalog number: 291940 )
- Complete Supplemental Mixture without Leucine (CSM-leu) (Sunrise Science, catalog number: 1005-010 )
- Complete Supplemental Mixture (CSM) (SunriseScience, catalog number: 1001-010 )
- Oleic acid (MP Biomedicals, catalog number: 0215178125 )
- Tween 20 (Sigma-Aldrich, catalog number: P9416-50ML )
- LB broth (Sigma-Aldrich, catalog number: L3022-1KG )
- Ampicillin (Sigma-Aldrich, catalog number: A0166 )
- YPD media/agar (see Recipes)
- SD-leu media/agar (see Recipes)
- SD oleic acid agar (see Recipes)
- LB agar (see Recipes)
Equipment
- Pipettes (Gilson, model: PIPETMANTM Variable Volume, catalog number: F167370 )
- Benchtop microcentrifuge (Eppendorf, model: 5424 , catalog number: 022620401)
- PCR thermocycler (Bio-Rad Laboratories, model: T100TM, catalog number: 1861096 )
- Incubation shaker (Infors, model: Multitron Standard )
- Incubator (Thermo Fisher Scientific, Thermo ScientificTM, model: HerathermTM IGS60, catalog number: 51028063 )
- Gel electrophoresis tank (Bio-Rad Laboratories, model: Wide Mini-Sub®, catalog number: 1704468 )
- Gel electrophoresis power supply (Bio-Rad Laboratories, model: PowerPacTM Basic, catalog number: 1645050 )
- Gel imager (Bio-Rad Laboratories, model: Gel DocTM XR+, catalog number: 1708195 )
Procedure
文章信息
版权信息
© 2018 The Authors; exclusive licensee Bio-protocol LLC.
如何引用
Misa, J., Schwartz, C. and Wheeldon, I. (2018). Design of Hybrid RNA Polymerase III Promoters for Efficient CRISPR-Cas9 Function. Bio-protocol 8(6): e2779. DOI: 10.21769/BioProtoc.2779.
分类
分子生物学 > DNA > DNA 修饰
微生物学 > 微生物遗传学 > 诱/突变
您对这篇实验方法有问题吗?
在此处发布您的问题,我们将邀请本文作者来回答。同时,我们会将您的问题发布到Bio-protocol Exchange,以便寻求社区成员的帮助。
Share
Bluesky
X
Copy link